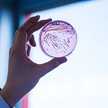
E. coli: Gefährlicher Stamm entdeckt

Thema: Studien
Artikel zum Thema
Alzheimer Nährstoff-Joghurt gegen das Vergessen
Eine kausale Behandlung von Alzheimer-Patienten gibt es derzeit nicht, die verfügbaren pharmakotherapeutischen Maßnahmen zielen darauf ab, die Symptome zu... Mehr»
Schmerzmittel Portale warnen vor Ibuprofen
„Gesundheitsämter warnen vor der Einnahme von Ibuprofen“, mahnten die Internetportale „Ohmymag“ sowie Gentside im September. Das Schmerzmittel könne... Mehr»
Formula-Diäten Warum Almased Apotheker braucht
Almased ist zwar als Lifestyle-Produkt bekannt, doch unterstützend kann es leitliniengerecht bei adipösen Patienten als Einstieg zur Gewichtsreduktion... Mehr»
Abwasseraufbereitung Arzneimittelrückstände könnten Insekten bedrohen
Antibiotika und Hormone im Wasser können Forschern zufolge auch eine Gefahr für Insekten werden. So nehmen etwa bestimmte Schmetterlinge den Arzneimittelmix... Mehr»
Der Kampf gegen die Tuberkulose-Epidemie geht verloren, wenn die internationalen Anstrengungen nicht verstärkt werden. Dieses ernüchternde Fazit zieht die... Mehr»
Wissenschaftspreis Phoenix feiert Pharmazie-Profs
Der Großhändler Phoenix hat innovative Forschungsarbeiten mit dem Pharmazie Wissenschaftspreis 2017 gewürdigt. Wissenschaftler von vier Universitäten... Mehr»
Rivaroxaban Neue Indikation für Xarelto 10 mg
Der orale Faktor-Xa-Inhibitor Rivaroxaban hat in der Stärke 10 mg die Zulassung für ein weiteres klinisches Einsatzgebiet erhalten. Die Entscheidung ist auf die... Mehr»
Signaltransduktion Liebestanz der Rezeptoren
Rezeptoren im Livestream: Wissenschaftler der Julius-Maximilian-Universität (JMU) in Würzburg haben erstmals Rezeptoren live beobachtet. Sie haben zudem... Mehr»
Antibiotikaresistenzen E. coli: Gefährlicher Stamm entdeckt
Gefährlicher Keim: Eigentlich ist der ohnehin im Darm lebende Bakterienstamm Escherichia coli harmlos. Nur einige Stämme können Infektionen auslösen, wenn sie... Mehr»
Krebsmedikamente Studie: Teure Medikamente ohne Nutzen
Krebsmedikamente werden oft ohne Nutzen zugelassen: Mitherausgeberin des British Medical Journal (BMJ) Deborah Cohen erhebt schwere Vorwürfe gegen die... Mehr»
Medien zum Thema
- 1